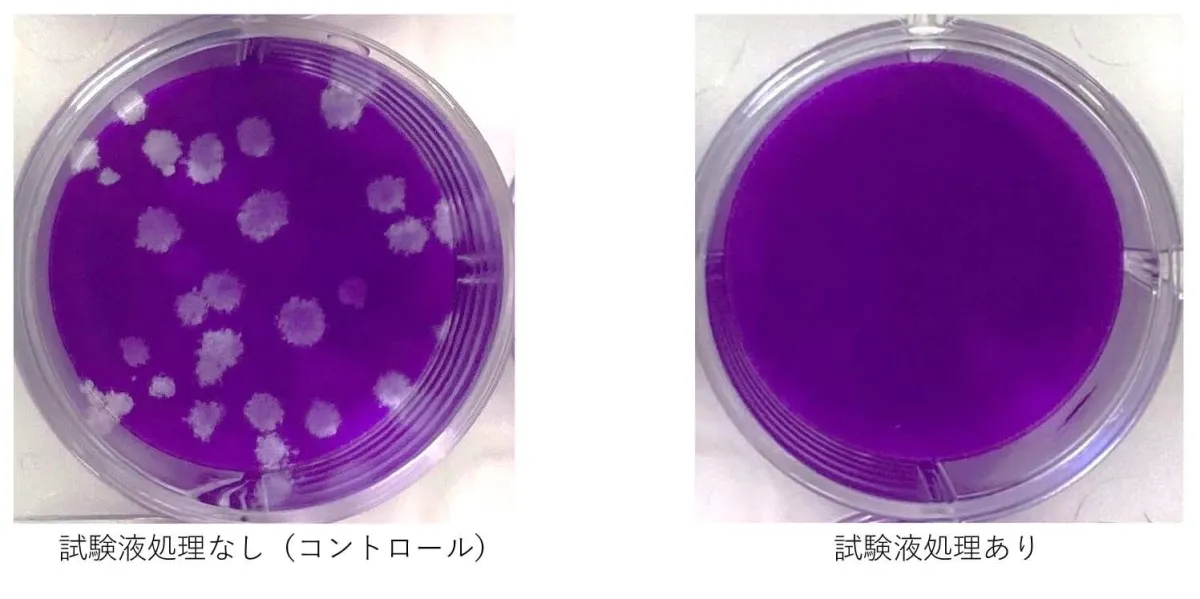

奈良県立医科大学実証!驚異のウイルス不活化効果!Rejuveシステム社製トリートメントジェルが新型コロナウイルスに効果を発揮
奈良県立医科大学実証!驚異のウイルス不活化効果!Rejuveシステム社製トリートメントジェル
株式会社リジュベネーションシステム社(神戸市東灘区)が開発したトリートメントジェルが、新型コロナウイルス(SARS-CoV-2)の不活化に効果を示すことが、奈良県立医科大学の実験で実証されました。
このトリートメントジェルは、顔やボディのマッサージに使用される製品で、200mlのチューブ入り。蓮科植物をバイオ発酵させた泥炭抽出物を主成分とし、各種アミノ酸、ビタミン、ミネラル、糖鎖栄養素などのナノコロイド抽出液を濃縮したゲルに、天然成分のグレープフルーツ種子エキスを配合しています。マッサージ後には、ジェルを洗い流すか拭き取ります。
奈良県立医科大学での試験
奈良県立医科大学では、このトリートメントジェルを用いて、新型コロナウイルスの不活化効果を試験管内で検証しました。ウイルスとジェルを混合し、0時間、1時間、2時間後にウイルス量を測定した結果、1時間後にはウイルス量は99.974%減少、2時間後には検出限界以下(99.996%以上の減少)にまで減少することが確認されました。この試験は、株式会社K&S(和泉市)の依頼に基づいて実施されました。
驚異的な効果と安全性
試験結果から、このトリートメントジェルが新型コロナウイルスを不活化することに高い効果を示すことが明らかになりました。ただし、この試験は試験管内での実験であり、飛沫感染予防や空気中ウイルスへの効果、人体への効果については確認されていません。あくまで、試験管内でのウイルス不活化効果を実証したものです。
株式会社リジュベネーションシステムについて
株式会社リジュベネーションシステムは、医薬部外品やスキンケア化粧品、機能性表示食品の製造販売を行う企業です。「安心・安全」を第一に、効果が期待できるこだわりの商品開発を行い、美と健康に貢献することを目指しています。
製品概要
製品名:トリートメントジェル
容量:200ml
主成分:蓮科植物由来泥炭抽出物、各種アミノ酸、ビタミン、ミネラル、糖鎖栄養素、グレープフルーツ種子エキス
用途:顔、ボディマッサージ
本件に関するお問い合わせ
販売元:株式会社リジュベネーションシステム
URL:https://www.reju.jp
お問い合わせ:[email protected] TEL: 06-6311-2220(武田・吉田)
免責事項
本記事は、奈良県立医科大学の実験結果に基づいて作成されていますが、医学的なアドバイスを意図したものではありません。新型コロナウイルス感染予防には、引き続き政府や専門機関の指示に従うことが重要です。
会社情報
- 会社名
- 株式会社リジュベネーション
- 住所
- 大阪府大阪市北区末広町3-13扇町松島ビル9F
- 電話番号
- 06-6311-2220
関連リンク
サードペディア百科事典: 奈良県 新型コロナウイルス リジュベネーションシステム トリートメントジェル 神戸市東灘区,和泉市
トピックス(科学)










【記事の利用について】
タイトルと記事文章は、記事のあるページにリンクを張っていただければ、無料で利用できます。
※画像は、利用できませんのでご注意ください。
【リンクついて】
リンクフリーです。